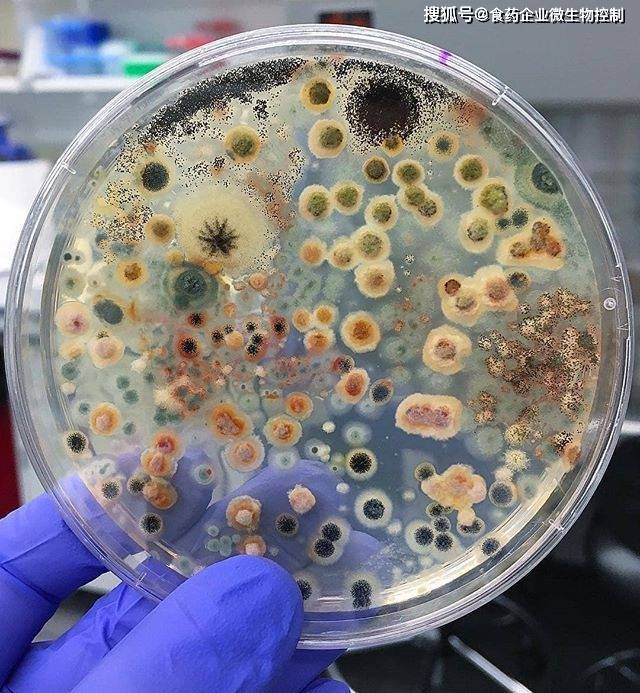
61 不应存在于任何加工过程中61 典型来源:- 水源污染(粪便污染)

粪便酵母菌

粪便中的真菌
图片尺寸992x620
酵母菌染色和未染色在100倍镜下
图片尺寸1920x2560
9张镜检图片总结粪便检查中的正常发现:酵母菌,植物,黏液,上皮细胞
图片尺寸354x550
9张镜检图片总结粪便检查中的正常发现:酵母菌,植物,黏液,上皮细胞
图片尺寸365x550
医生又看了一遍粪检说:你再看,啥叫什么也没有_虫卵_粪便_细胞学
图片尺寸597x448
9张镜检图片总结粪便检查中的正常发现:酵母菌,植物,黏液,上皮细胞
图片尺寸339x550
9张镜检图片总结粪便检查中的正常发现:酵母菌,植物,黏液,上皮细胞
图片尺寸450x333
粪便人体酿母菌(食谱|细胞生物学)人体酵母菌为一种寄生于人体中的
图片尺寸300x270
9张镜检图片总结粪便检查中的正常发现:酵母菌,植物,黏液,上皮细胞
图片尺寸450x304
9张镜检图片总结粪便检查中的正常发现:酵母菌,植物,黏液,上皮细胞
图片尺寸450x337
宝宝拉这样的便是怎么回事,现在正在喂蒙脱石散,布拉酵母菌散
图片尺寸612x816
5月龄拉肚子痊愈过程,附便便图对照
图片尺寸1706x1704
粪便中查到酵母菌怎么办
图片尺寸600x600
9张镜检图片总结粪便检查中的正常发现:酵母菌,植物,黏液,上皮细胞
图片尺寸359x500
酵母菌的介绍
图片尺寸900x675
有机肥料生物腐熟剂粪便发酵剂秸秆还田酵母菌em有益微生物菌种剂
图片尺寸800x800
关于宝宝便便那些事75新手麻麻拿走不谢
图片尺寸1080x1439
这类益生菌不能长期补充请家长们注意了
图片尺寸1080x1439
100 x)图2:高倍视野(400x)图1:虫体涂片 (1x)形态学检查如下:粪便常规
图片尺寸473x447
61 不应存在于任何加工过程中61 典型来源:- 水源污染(粪便污染)
图片尺寸640x693